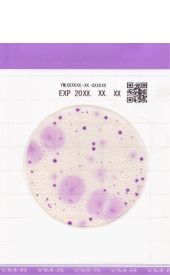

Тест-пластины Easy Plate YM-R для экспресс-определения дрожжей и плесеней
Характеристики:
Производитель — Kikkoman Biochemifa
Микроорганизмы — Дрожжи и плесневые грибы
Время инкубации — 48 ч
Упаковка — 4 х 25 шт.
Тест-пластины Easy Plate YM-R («R» – rapid, быстрый) для экспресс-определения дрожжей и плесеней за 48 часов состоят из нижней водостойкой подложки, покрытой в центральной части застывшим питательным гелем и верхней прозрачной пленки с нанесенной сеткой. Помимо микробиологической среды в состав геля включены окислительно-восстановительные индикаторы для последующей идентификации анализируемых микроорганизмов по характерному окрашиванию их колоний в фиолетовый цвет. Тест-пластины Easy Plate YM-R предназначены для быстрого выявления дрожжей и плесеней в пищевых продуктах и напитках как альтернатива классическому методу микробиологического анализа в чашках Петри и имеют значительно более короткое время инкубации, чем при посеве на агаровые среды. Тест-пластины Easy Plate YM-R компактны, просты в использовании и образуют низкий уровень отходов в процессе тестирования.
1. Легко различимые яркоокрашенные колонии за 48 часов
Колонии приобретают фиолетовый цвет, что позволяет легко идентифицировать и подсчитать колонии. Четкое окрашивание облегчает их визуальную оценку даже при наличии остатков пищи или других контаминантов.
2. Высокая корреляция с классическими методом
Данные микробиологического анализа различных пищевых продуктов на пластинах Easy Plate AC хорошо коррелируют с результатами подсчета колоний на агаризованных чашках Петри.

Корреляционный анализ результатов параллельных микробиологических тестов (Easy Plate YM-R / PDA и Easy Plate YM-R / DRBC Agar). Данные также подтверждены Center for Fungal Consultation (Центр исследования грибов Токио, Япония).
Купить Тест-пластины Easy Plate YM-R для экспресс-определения дрожжей и плесеней можно в нашей компании и заказать доставку в следующие города: Абакан, Анадырь, Архангельск, Астрахань, Барнаул, Белгород, Биробиджан, Благовещенск, Брянск, Великий Новгород, Владивосток, Владикавказ, Владимир, Волгоград, Вологда, Воронеж, Горно-Алтайск, Грозный, Екатеринбург, Иваново, Ижевск, Иркутск, Йошкар-Ола, Казань, Калининград, Калуга, Кемерово, Киров, Кострома, Краснодар, Красноярск, Курган, Курск, Кызыл, Липецк, Магадан, Магас, Майкоп, Махачкала, Москва, Мурманск, Нальчик, Нарьян-Мар, Нижний Новгород, Новосибирск, Омск, Оренбург, Орёл, Пенза, Пермь, Петрозаводск, Петропавловск-Камчатский, Псков, Ростов-на-Дону, Рязань, города Республики Крым, Санкт-Петербург, Салехард, Самара, Саранск, Саратов, Севастополь, Симферополь, Смоленск, Ставрополь, Сыктывкар, Тамбов, Тверь, Томск, Тула, Тюмень, Улан-Удэ, Ульяновск, Уфа, Хабаровск, Ханты-Мансийск, Чебоксары, Челябинск, Черкесск, Чита, Элиста, Южно-Сахалинск, Якутск, Ялта, Ярославль и др.
Информация, представленная на сайте, не является публичной офертой.